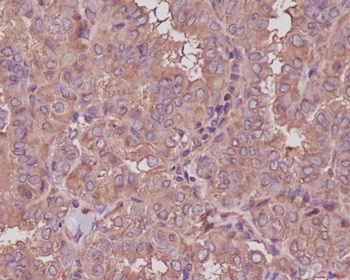
beta III Tubulin TUBB3 Rabbit Monoclonal Antibody

You have no items in your shopping cart.
- beta III Tubulin Rabbit mAb Antibody [orb1952000]
FC, ICC, IHC, IP, WB
Human, Mouse, Rat
Rabbit
Monoclonal
Unconjugated
50 μl, 100 μl - beta III Tubulin Rabbit mAb Antibody [orb1952002]
FC, ICC, IHC, IP, WB
Human, Mouse, Rat
Rabbit
Monoclonal
Unconjugated
100 μl, 50 μl - Beta3-tubulin Antibody [orb393346]
IHC, WB
Human, Mouse, Rat
Rabbit
Polyclonal
Unconjugated
50 μl, 100 μl, 200 μl, 30 μl - Beta-tubulin Antibody [orb393348]
IHC, WB
Human, Mouse, Rat
Rabbit
Polyclonal
Unconjugated
200 μl, 50 μl, 100 μl, 30 μl - Chicken Tubulin beta 3 Antibody [orb3011859]
IF, IHC-Fr, WB
Human, Mouse, Rat
Gallus
Unconjugated
100 μl, 50 μl ICC, IF, IHC, IP, WB
Human, Mouse, Rat
Rabbit
Monoclonal
Unconjugated
100 μlFC, ICC, IF, IHC, IP, WB
Human, Mouse, Rat
Rabbit
Monoclonal
Unconjugated
100 μl- TUBB3 Antibody [orb632967]Featured

ELISA, IF, IHC, WB
Human, Mouse, Rat
Mouse
Monoclonal
Unconjugated
50 μg, 100 μg